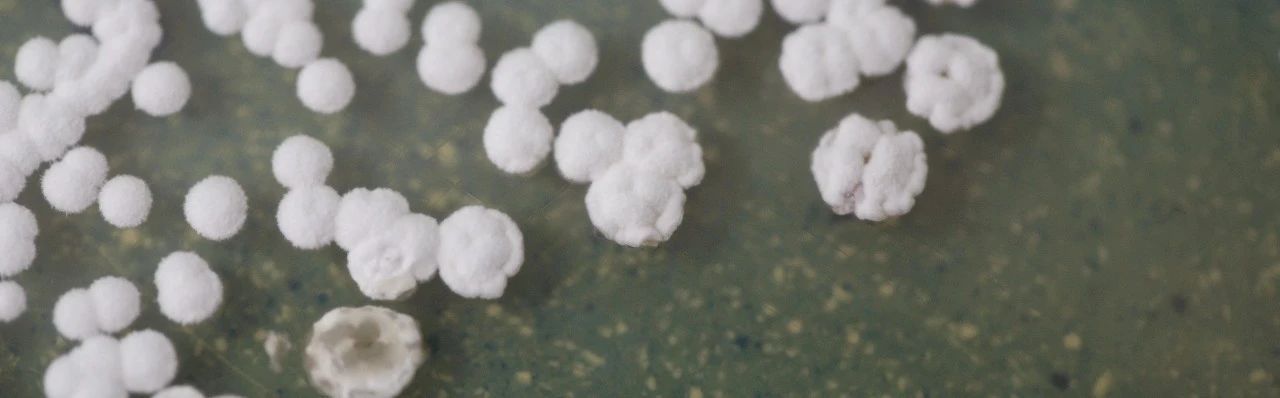
图片

咨询热线
400-810-0881
限时促销 | ATCC微生物组学标准品劲爆85折!
微生物组学(Microbiome)是一门新兴的跨学科领域,专注于研究生物体内微生物群落的结构、功能、互作以及与宿主的关系。
微生物组学研究需要对很多种微生物组合做相应的研究,其复杂性使得检测标准化变得很有挑战性,为此ATCC开发了各种分析优化和质控的微生物组学标准品。
限时促销
惊爆价
Microbiome
即日起至7.31日止
终端用户
订购ATCC 微生物组学标准品
即可立享受85折优惠!
参与的具体产品
详情如下
表 ATCC 微生物组标准品部分清单

根据应用方向不同,ATCC将不同系统产品进行了详细分类。
例如:
1、包含不同人体部位的标准品,口腔微生物组、皮肤微生物组、肠道微生物组、阴道微生物组;
2、提高检测一致性的全菌株模拟微生物组(10种微生物、20种微生物等);
3、病原体检测方向的微生物组;
4、模拟人类真菌群落的标准品及人类病毒组标准品等相关产品。
如有产品订购或咨询需求,欢迎联系。
北京:010- 84415670
上海:010- 84415767
广州:010- 84415643
天津:010- 84415615
成都:010- 84415614
杭州:010- 84415684
研发背景
微生物组包括细菌、真菌、病毒等多种微生物,它们在人体、动植物、土壤、水体等生态系统中广泛存在,对环境的生物地球化学循环和生态系统的稳定性起着重要作用。
微生物组学的研究起源于对微生物生态学的兴趣和技术发展,尤其是高通量测序技术的进步使得大规模微生物群落分析成为可能。

在过去几十年中,微生物组学已经从定性描述发展到定量分析,并开始探索微生物群落在健康和疾病中的作用。
应用领域
因此需要在研究的过程中提供一个已知且可靠的参考,以评估微生物组学的分析流程是否准确无误。
这种标准品可以帮助研究者确认微生物组分析流程的可靠性,比如在进行微生物多样性调查、微生物群落功能预测以及微生物组关联分析时,确保所得出的结果具有较高的可信度。
微生物组学标准品还可以用于微生物组相关设备的校准和验证,比如在微生物组测序平台上,通过使用标准品可以校准和验证测序仪器的性能,确保测序数据的质量和一致性。这对于保证微生物组数据的准确性和可重复性至关重要。
此外,微生物组标准品在微生物组研究中还扮演着质量控制的角色。通过对标准品的分析,研究者可以监控实验过程中的潜在偏差,从而确保实验数据的真实性和可靠性。

常规实验流程图
京公网安备11010502040370号 技术支持:青云软件